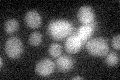
YDR245W
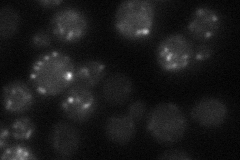
YDR245W
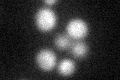
YDR245W

View description
Subunit of a Golgi mannosyltransferase complex also containing Anp1p, Mnn9p, Mnn11p, and Hoc1p that mediates elongation of the polysaccharide mannan backbone; membrane protein of the mannosyltransferase family
Localization:
Intensity:
Fold change:
Significance:
-
C’ GFP library in SD
below threshold14.07 -
N' NOP1pr-GFP in SD

ER,punctate69.3194 -
N' TEF2pr-mCherry in SD

ER,punctate52.4612 -
N' NATIVEpr-GFP in SD
punctate27.8175 -
N' TEF2pr-VC and Cyto-VN in SD

punctate35.2342 -
C’ GFP library in SD+DTT
cytosol14.641.04No -
C’ GFP library in SD+H2O2

cytosol15.321.08No -
C’ GFP library in Starvation Media

cytosol17.551.24No -
C’ GFP library on the background of Pup2-DaMP

below threshold -
C’ GFP library on the background of CCT mutant

below threshold14.4381.02558No
